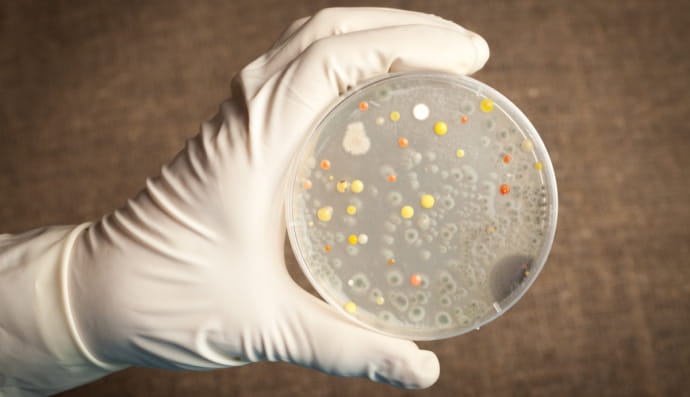
сибірська виразка

Ігор Кузін
В Україні можуть запровадити карантин – Ігор Кузін
У деяких областях спостерігається перевищений епідемічний поріг
На Рівненщині зафіксували випадок захворювання на новий підваріант COVID-19 – Кузін
Випадок інфікування зафіксували у 20-річного пацієнта
Новий штам коронавірусу Pirola поширюється світом: чи загрожує він Україні – МОЗ
Експерти назвали симптоми нового COVID-варіанту
В Україні зростає захворюваність на COVID-19 – Кузін
"У людей літнього віку, з важкими захворюваннями, ризик померти вищий"
Серед українців спадає бажання вакцинації і зростає кількість госпіталізацій
За минулий тиждень госпіталізували 3 тис інфікованих коронавірусом
В Україні зростає кількість смертей від COVID-19 – Кузін
"Летальні випадки на високому рівні"
У деяких областях України можуть повернути карантин
Загальнодержавний карантин не планується
"Становлять найбільшу загрозу": Кузін розповів про шість небезпечних інфекційних захворювань для України
"З цим ми зіткнемося через деякий час"
Коли всім українцям дозволять щепитися другою бустерною дозою вакцини від COVID-19 – Кузін
Кількість заражень на ковід зростає
Кількість захворювань зростає: в Україні розпочалася осіння хвиля пандемії COVID-19 – Кузін
Разом із цим показник госпіталізацій також стрімко зріс
В Україні можуть запровадити вакцинацію четвертою дозою – Кузін
У МОЗ опрацьовують ці рекомендації
В Україні існує ризик появи сибірської виразки – Кузін
Нова небезпека?
Лікарі мають чіткий алгоритм дій: в Україні очікують на мавпячу віспу – Кузін
У МОЗ вже не заперечують ймовірність появи захворювання і у нашій державі
Мавпяча віспа в Україні: головний санлікар Кузін розповів про ймовірність поширення вірусу
Це небезпечне захворювання виявили вже у 14 країнах світу
Як виокремити агресивну Дельту серед інших штамів – Ігор Кузін
Санлікар розповів про особливості найагресивнішого штаму